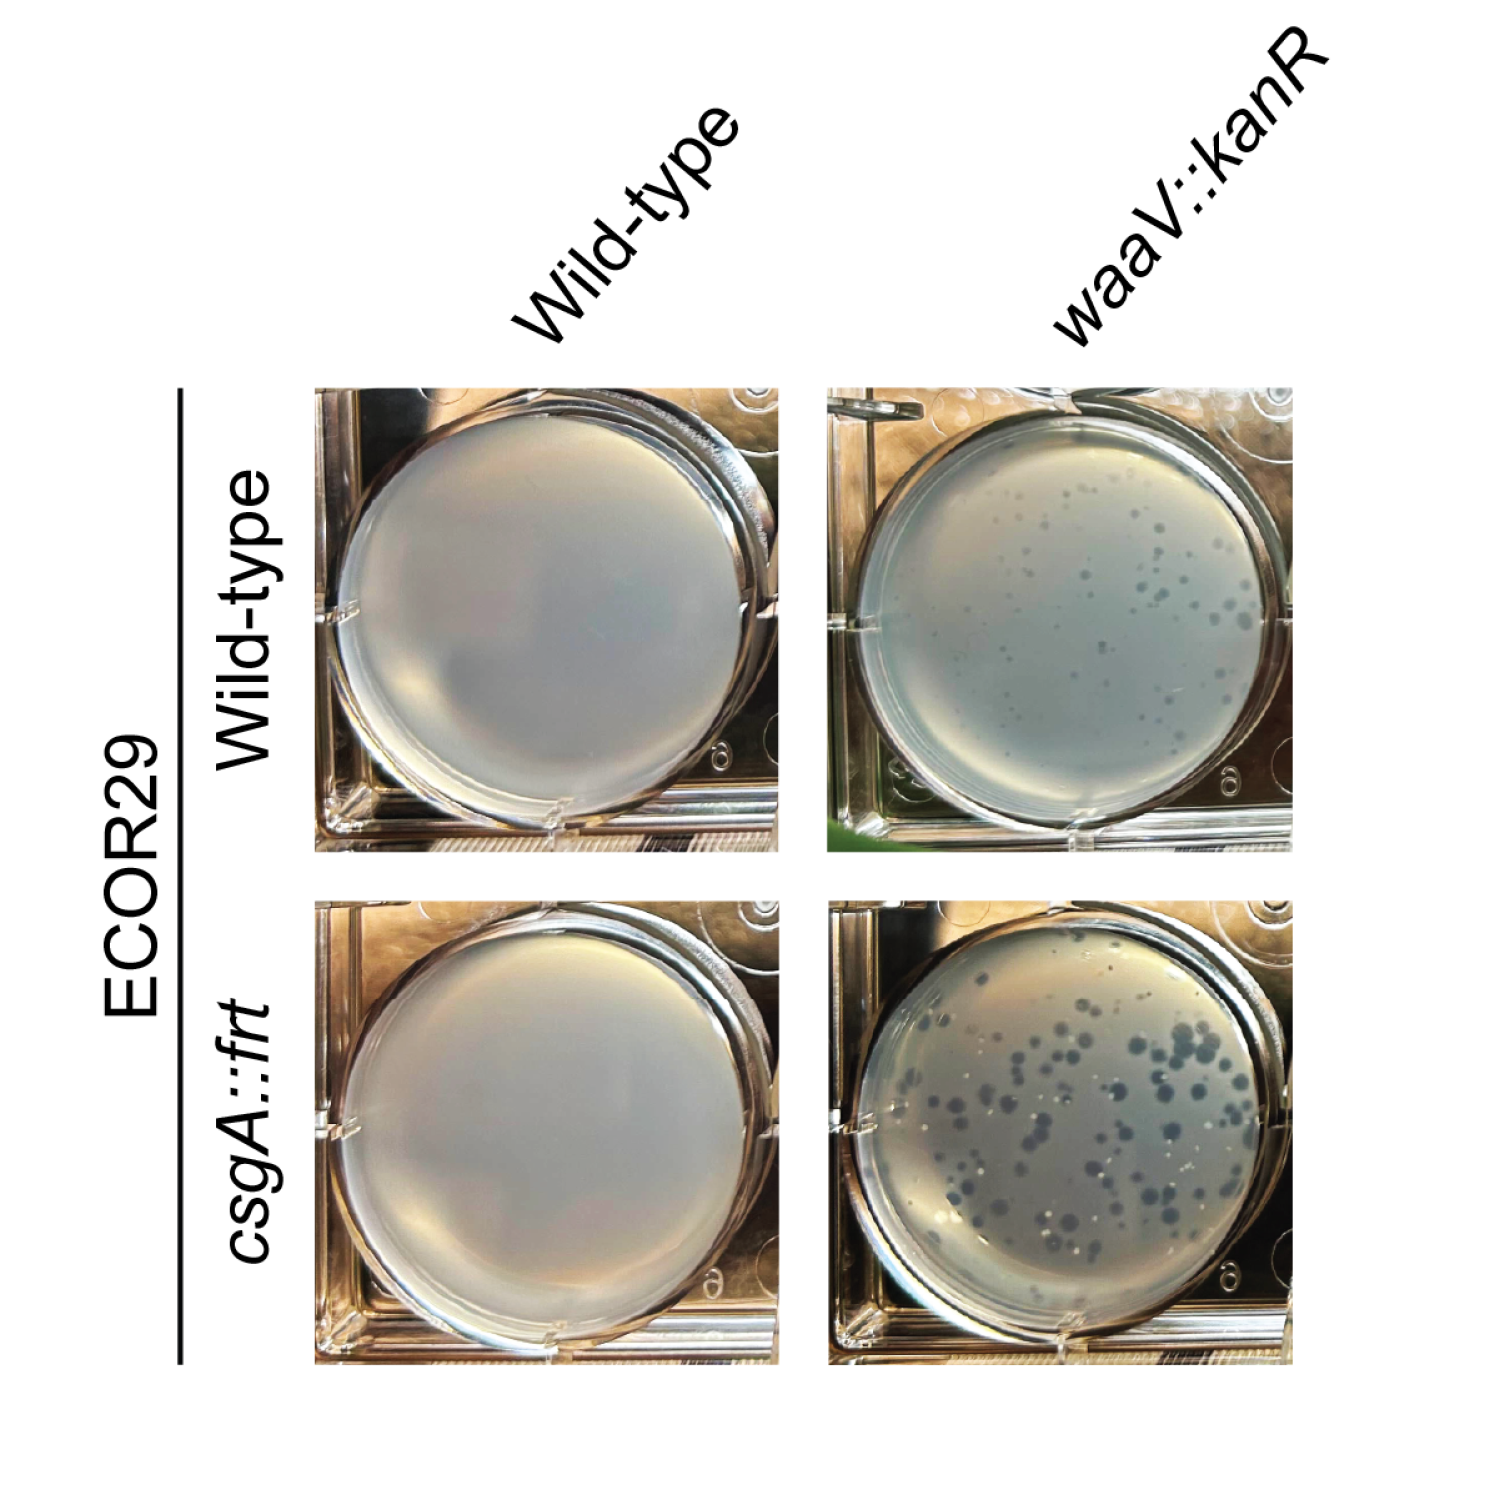

Updates from the lab
2025

October 1st, 2025
Our work on the Panoptes system is published Nature!
"The Panoptes system uses decoy cyclic nucleotides to defend against phage" by Sullivan et al. Check out the full paper here.
September 29th, 2025
Our work on curli-independent defense against Bdellovibrio is published Microbiology Spectrum!
"Curli-independent defense against Bdellovibrio bacteriovorus in E. coli" by Sayegh et al. Check out the full paper here.

"Functional amyloid proteins confer defence against predatory bacteria" by Ledvina et al. Check out the full paper here.

July 2nd, 2025
Our work on phage triggers is deposited on BioRxiv!
"Identifying phage proteins that activate the bacterial innate immune system" by Nagy et al. Check out the full preprint here!

June 24th, 2025
Nathan Bullen is awarded the Jane Coffin Childs Fellowship!
This prestigious three-year award will support his work studying molecular mechanisms of how bacteria defend themselves against diverse threats.
Well done Nathan!
June 1st, 2025
Ashley Sullivan is awarded the NIH Ruth L. Kirschstein National Research Service Award
The Ruth L. Kirschstein National Research Service Award (F31), presented by the National Institutes of Health/National Institute of Allergy and Infectious Diseases, recognizes outstanding predoctoral students who are pursuing full-time research-based dissertation research in biomedical science. The NIAID F31 will support Ashley for the next 2.5 years. Well done Ashley!

May 30th, 2025
Our work on NLR-related proteins that defend against RNA phages is published PLoS Biology!
"DnaJ mediates phage sensing by the bacterial NLR-related protein bNACHT25" by Conte et al. Check out the full paper here.

April 8th, 2025
Laurel Robbins is awarded the NSF GRFP!
The Graduate Research Fellowship Program (GRFP), presented by the National Science Foundation, recognizes outstanding graduate students who are pursuing full-time research-based master's and doctoral degrees in science, technology, engineering, and mathematics. The NSF GRFP will support Laurel for the next 3 years. Well done Laurel!

March 28th, 2025
Our work on the Panoptes antiphage system is deposited on BioRxiv!
"A minimal CRISPR polymerase produces decoy cyclic nucleotides to detect phage anti-defense proteins" by Sullivan et al. Check out the full preprint here!
2024

December 17th, 2024
Our work on AlphaFold screens using bacterial NLR-related protein is deposited on BioRxiv!
"A bacterial NLR-related protein recognizes multiple unrelated phage triggers to sense infection" by Kibby et al. Check out the full preprint here!

June 4th, 2024
Our work on the mechanism of bacterial NLR-related protein phage-sensing is deposited on BioRxiv!
"Phage detection by a bacterial NLR-related protein is mediated by DnaJ" by Conte et al. Check out the full preprint here!

MAY 20TH, 2024
Aaron is named a 2024 Burroughs Wellcome Fund Investigator in the Pathogenesis of Infectious Disease
The PATH is a highly competitive award program that provides $500,000 over five years to study pathogenesis. The program intends to give recipients the freedom and flexibility to pursue new avenues of inquiry, stimulating higher-risk research projects that hold potential for significantly advancing our understanding of how infectious diseases work and how health is maintained.
- Read the press release from the Burroughs Wellcome Fund
- Check out more information on our lab's funding
May 6th, 2024
Laurel Robbins joins the lab!
Laurel joins the lab as a Ph.D. student in Biochemistry and a member of the IQ Biology Graduate Group.

The Harold M. Weintraub Graduate Student Award, presented by the Fred Hutch Cancer Center, recognizes exceptional achievement in graduate studies in the biological sciences. The twelve awardees will present their thesis work at a symposium held on May 3rd. Well done Emily!
- Read the story in the Colorado Arts and Sciences Magazine
- Read the press release from the Fred Hutch

FEBRUARY 28TH, 2024
Our review of bacterial and eukaryotic immune systems is published in Nature Reviews Microbiology!
"Conservation and similarity of bacterial and eukaryotic innate immunity" by Ledvina and Whiteley. Check out the full paper here.
2023

The American Society for Microbiology (ASM) Award for Early Career Basic Research recognizes an early career investigator with distinguished basic research achievements in the microbial sciences.
- Read the story in the Colorado Arts and Sciences Magazine
- Read the press release from the ASM

"Bacterial cGAS-like enzymes produce 2′,3′-cGAMP to activate an ion channel that restricts phage replication" by Tak et al. Check out the full preprint here.

JUNE 13TH, 2023
Aaron is named a 2023 Pew Biomedical Scholar!
The Pew Scholars Program in the Biomedical Sciences provides funding to young investigators of outstanding promise in science relevant to the advancement of human health. The program makes grants to selected academic institutions to support the independent research of outstanding individuals who are in their first few years of their appointment at the assistant professor level. Whiteley is one of 22 early career scientists who will receive four years of funding to spearhead innovative studies exploring human health and medicine.
- Read the story in the Colorado Arts and Sciences Magazine
- Read the press release from The Pew Charitable Trusts

MAY 31ST, 2023
A Blooming Scientist: Emily Kibby
Emily Kibby is profiled in the Department's Be a Biochemist series!

"Bacterial NLR-related proteins protect against phage" by Kibby et al. Check out the full paper here.

FEBRUARY 8TH, 2023
Our work on E1-E2 fusion proteins in bacteria is published in Nature!
"An E1–E2 fusion protein primes antiviral immune signalling in bacteria" by Ledvina and Ye et al. Check out the article about our work in CU Today.
2022

OCTOBER 4TH, 2022
Aaron is awarded the NIH Director’s New Innovator Award!
The NIH Director’s New Innovator Award Program supports exceptionally creative early career investigators who propose innovative, high-impact projects in the biomedical, behavioral or social sciences within the NIH mission. Our work is on Deciphering the crosstalk between bacteria and their mammalian hosts.
- Read the story in the Colorado Arts and Sciences Magazine
- Read the press release from the NIH

JULY 20TH, 2022
Our work on NLR-related proteins is deposited on BioRxiv!
"Bacterial NLR-related proteins protect against phage" by Kibby et al.

JUNE 1ST, 2022
The lab is awarded an AB Nexus Grant!
The AB Nexus Grant Program supports collaborative research between CU Boulder and CU Anschutz Medical School campuses. Our work is on Nucleotide Second Messengers at the Host-Pathogen Interface, in collaboration with Dr. Kelly S. Doran, PhD, (Department of Immunology and Microbiology), CU Anschutz.
- Read the announcement from the CU Boulder Office of Research and Innovation
- Read the story Catalyzing a Culture of Collaboration from CU Anschutz Medical Campus

JUNE 1ST, 2022
Aaron is named a 2022 Boettcher Investigator!
The Boettcher Foundation has named Aaron and 7 others to the 2022 class of Boettcher Investigators through the Boettcher Foundation’s Webb-Waring Biomedical Research Awards Program. The prestigious award supports promising, early career scientific researchers, allowing them to advance their independent research in Colorado and compete for major federal and private awards in the future. Each Boettcher Investigator will receive a $235,000 grant to support up to three years of biomedical research.
- Read the story in the Colorado Arts and Sciences Magazine
- See the announcment from the University of Colorado

MARCH 31ST, 2022
The lab's first manuscript is deposited on BioRxiv!
"cGASylation by a bacterial E1-E2 fusion protein primes antiviral immune signaling" by Ledvina and Ye et al.
FEBRUARY 10TH, 2022
Melissa is selected for the University of Regensburg Undergraduate Research Scholarship!
The University of Regensburg Undergraduate Research Scholarship is a competitve program that enables undergradraduates to participate in a 10-week research internship in Germany. Well done Melissa!
2021

OCTOBER 10TH, 2021
The lab is awarded the Mallinckrodt Foundation Grant!
Our lab was awarded its first grant! The Mallinckrodt Foundation Grant will support our work on antiphage signaling in bacteria.

This prestigious three-year award will support his work studying molecular mechanisms of the cGAS-STING pathway. Ceck out the departmental highlight.
Well done Uday!

JULY 1ST, 2021
Hannah Ledvina is awarded the Jane Coffin Childs Fellowship!
This prestigious three-year award will support her work studying molecular mechanisms of how bacteria resist phage infection. Check out the departmental highlight.
Well done Hannah!
APRIL 9TH, 2021
Rico Carale is awarded an Undergraduate Research Opportunity Program Grant!
Congrats Rico! We are looking forward to all the great science coming this summer.
FEBRUARY 18TH, 2021
Alfredo Vargas joins the lab!
Alfredo is joins the lab as an Undergraduate Researcher and Wuttke–Beckman Scholar
JANUARY 15TH, 2021
Rico Carale joins the lab!
Rico joins the lab as the first Undergraduate Researcher
2020

DECEMBER, 2020
Happy Holidays!
Emily Kibby's festive holiday cookies include a :classy_phage: sporting a monocle and moustache
Emily has been awarded two years of grant support from the NIH Graduate Training Program in Signaling and Cellular Regulation. Congrats Emily!

MAY 28TH, 2020
The lab reopens
Operating at <25% capacity, the lab resumes research! Time to unpack all the boxes...

MARCH 19TH, 2020
Lab meeting #1
Our first lab meeting! We move from in vivo & in vitro to in silico. The lab has transitioned to video conferencing for all meetings in the wake of the COVID-19 pandemic.
MARCH 14TH, 2020
The lab shuts it's doors
In order to #flattenthecurve, the lab has gone remote. Saying goodbye to the bench, it's time for everyone to brush up on their office ergonomics!

JANUARY, 2020
The Aaron Whiteley Lab opens!
The lab opens its doors and finds a home in JSCBB 2nd floor B-wing.